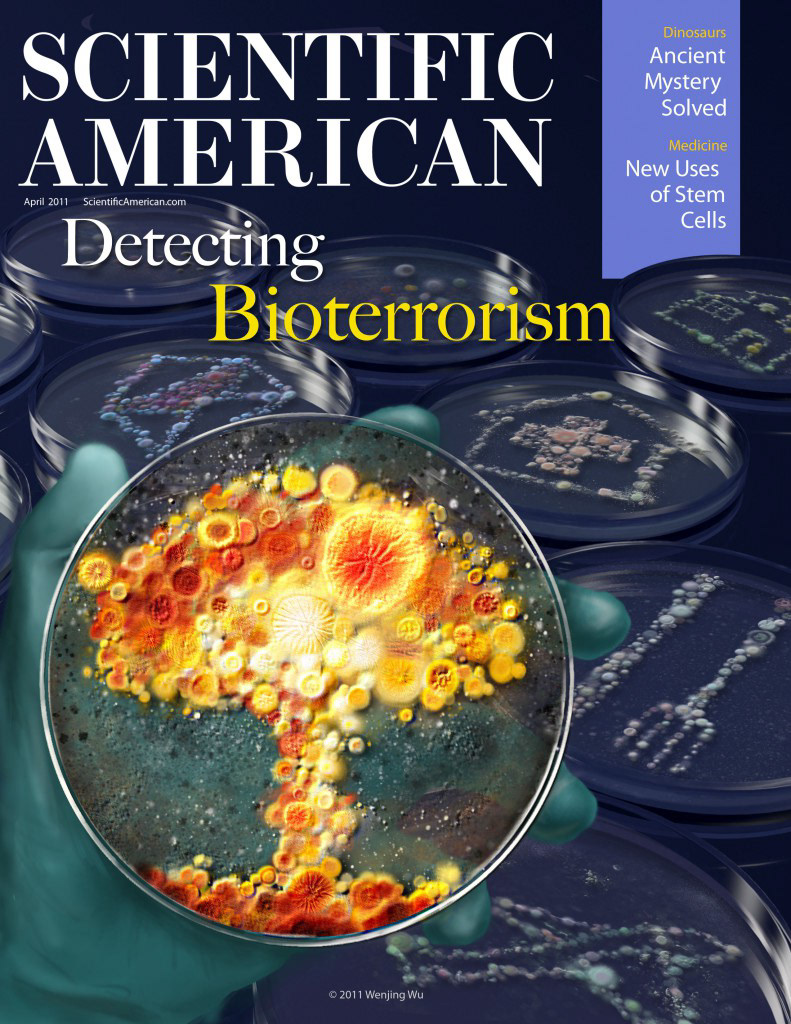
detecting bioterrorism cover illustration

tau protein in alzheimer's disease

hands of a cellist

PSMA graphic abstract

carbon dust hip bone painting

respiration of necturus maculosus

nasal reconstruction

base of skull with cranial nerves

cunningham clamp patient education

first aid - choking

photoshop painting exercise

left adrenalectomy

laparoscopic left adrenalectomy

sketch for total abdominal hysterectomy

total abdominal hysterectomy

vasculature of stomach, duodenum, pancrease and spleen

dynamic magnetic fields remote control apoptosis via nanoparticle rotation

collaborative innovation in drug discovery (book cover)

the dark side of RNAi technology

detecting bioterrorism cover illustration

diagonal upper gracilis (DUG) flap for breast reconstruction patient education

unstable chromosomes in cells editorial illustration

bladder cancer staging

cell reports editorial illustration

DNA transversion caused by smoking

Raman imaging technology in clinical application editorial illustration

gold nanoparticles editorial illustration

tiger in jungle editorial illustration

nanoparticles table of content illustration

proposed cover design for Cell

patient and physician interaction editorial illustration

cytotoxicity

colorectal cancer

blood cells in vessel editorial illustration

the construction of CAR T cell

cystoscopy

steps from sperm cryopreservation

bone mechanical microenvironment

nanoparticles binding to the inflammatory cytokins

trabeculae: low/normal/high bone mass

proposed cover for Cell Stem Cell